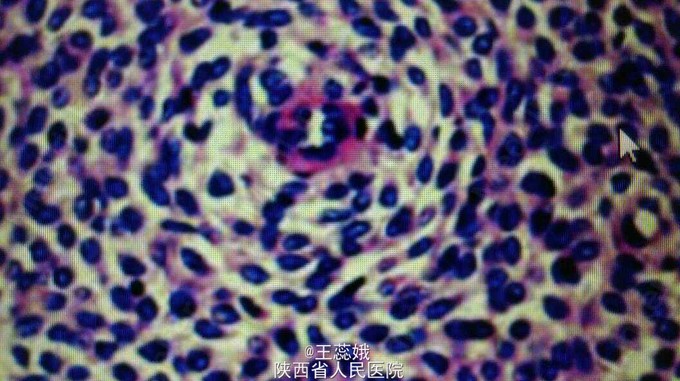

下载或打开 医联APP 查看完整评论
立即下载
打开APP
女,37岁,不规则阴道流血2月伴下腹部胀痛 子宫增大,病变位于宫底部呈不均质稍增强回声,边界不清

肿块最大经5cm,不同程度侵入子宫肌壁,切面灰白灰黄色,无明明显出血坏死
镜下见弥漫薄壁的螺旋小血管,肿瘤细胞呈同心圆排列,CD10阳性

全子宫切除术,肿瘤起源于子宫内膜间质细胞,是女性生殖道罕见恶性肿瘤,恶性程度相差很大,普遍具有预后不良的特征,目前认为最有效方法是手术切除,全子宫及双附件是早期低级别的标准方法,手术后可辅以放疗,化疗,孕激素治疗及观察。